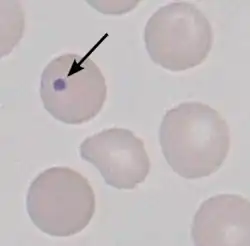
photomicrograph

Howell–Jolly body
A Howell–Jolly body is a cytopathological finding of basophilic nuclear remnants (clusters of DNA) in circulating erythrocytes. During maturation in the bone marrow, late erythroblasts normally expel their nuclei; but, in some cases, a small portion of DNA remains. The presence of Howell–Jolly bodies usually signifies a damaged or absent spleen, because a healthy spleen would normally filter such erythrocytes.
The Howell–Jolly body is named after William Henry Howell[1] and Justin Marie Jolly.[2][3]
Appearance
This DNA appears as a basophilic (purple) spot on the otherwise eosinophilic (pink) erythrocyte on a standard H&E stained blood smear. These inclusions are normally removed by the spleen during erythrocyte circulation, but will persist in individuals with functional hyposplenia or asplenia.
Causes
Howell–Jolly bodies are seen with markedly decreased splenic function. Common causes include asplenia (post-splenectomy) or congenital absence of spleen (right atrial appendage isomerism). Spleens are also removed for therapeutic purposes in conditions like hereditary spherocytosis, trauma to the spleen, and autosplenectomy caused by sickle cell anemia. Other causes are radiation therapy involving the spleen, such as that used to treat Hodgkin lymphoma.

Howell–Jolly bodies are also seen in amyloidosis, severe hemolytic anemia, megaloblastic anemia, hereditary spherocytosis, and myelodysplastic syndrome (MDS). The bodies can also be seen in premature infants.
References
- ^ Howell, W. H. (1890). "The life-history of the formed elements of the blood, especially the red blood corpuscles" (PDF). Journal of Morphology. 4 (1). New York: 57–116. doi:10.1002/jmor.1050040105. S2CID 85700639.
- ^ synd/1596 at Whonamedit?
- ^ Jolly, J (1908). Recherches sur la formation des globules rouges des mammifères (in French). Vol. 58. Paris: Comptes rendus de la Société de Biologie. pp. 528–531.